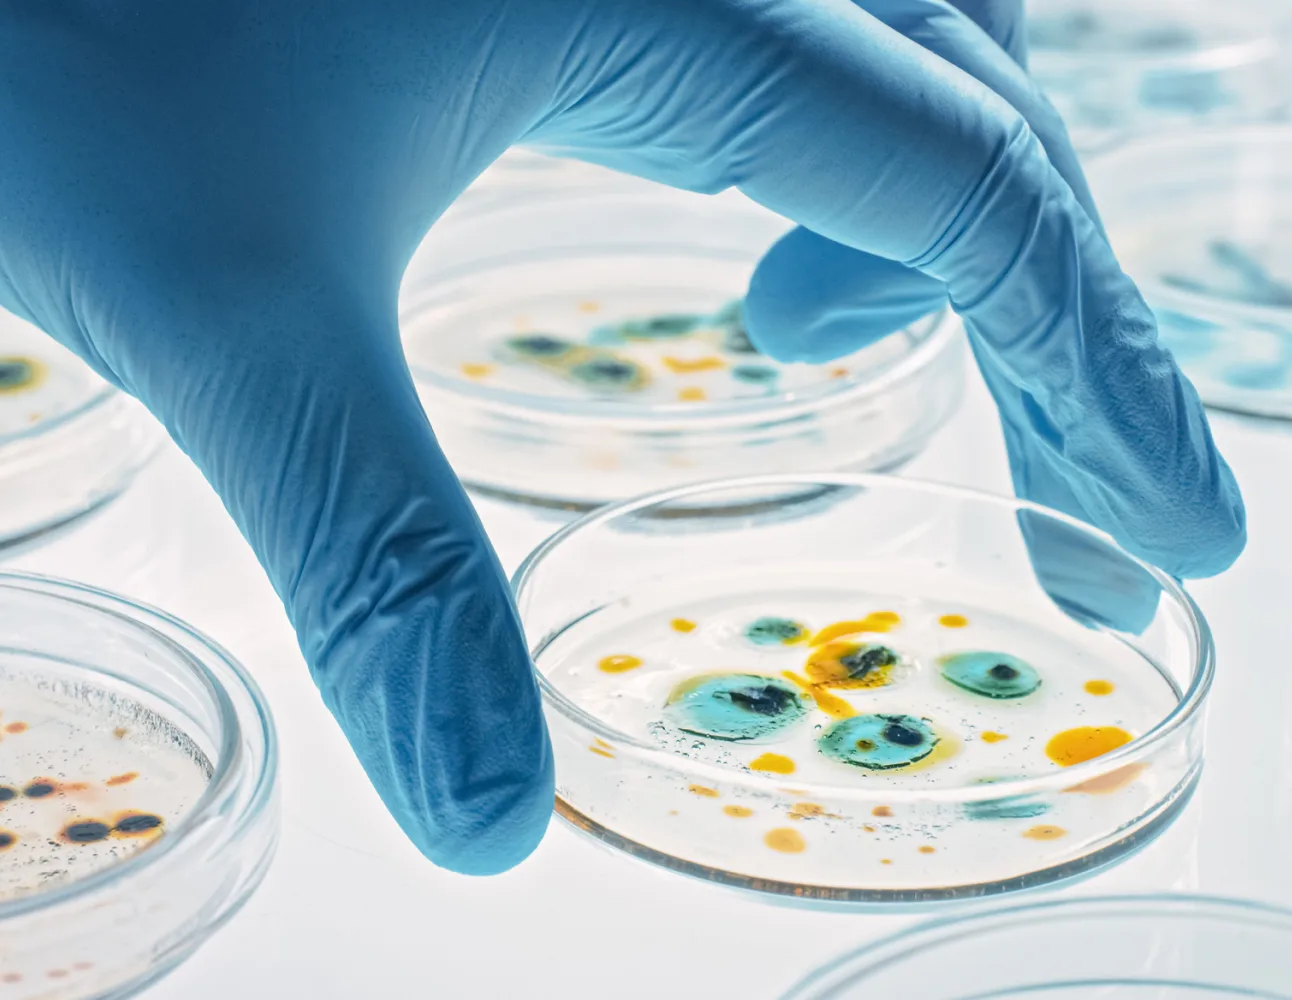
Mask group (3)

Global Plant Protein Development and Application Expert
We specialize in the development, manufacturing and sales of soy proteins and provide customized solutions, to promote the innovation and application of plant protein.
Enrich life with Treasure of Proteins
We empower the nutrition of human, animal and microorganism with high-quality protein, making health and sustainability accessible to every aspect of daily life around the world.
Over 20 years of industry expertise and full supply chain production experience.
Relying on a mature supply chain, strong R&D capabilities and a complete quality system, we provide customized protein solutions to meet diverse market demands.
Environmental sustainability and social responsibility
We adhere to the principles of environmental protection, responsibility and governance from sourcing to product delivery, and are committed to promoting the sustainable development of the industry and society.
/
Products & Services
Products & Services

Soy Proteins
Our high-quality soy protein can improve functional and nutritional value in meats, meat alternatives and nutritional products.

Other Plant Proteins
Our broad plant protein options provide tailored and innovative solutions for a variety of food and beverage applications.

Flakes and Flours
The multi-functional, minimally processed flakes & flours are ideal for bakery products, fermentation and animal & pet foods.

Fibers
Deliver highly functional properties, health benefits and cost-effectiveness in applications such as food and pet products.

Oils
Our non-GMO, high-quality soy oil is a versatile and nutritional option to meet the needs of food and pet food industry.

Health Nutrition Ingredients
Tailored for nutritional beverages, foods and special medical applications to meet the functional and clear label solution needs.

Pet Nutrition Ingredients
High-quality, human-grade ingredients can deliver taste, nutrition and functionality values in pet foods, treats and supplements.

Feed Nutrition Ingredients
Our nutrition-optimized, sustainable and stably sourced feed ingredients can optimize livestock health, performance and production.
Microbial Fermentation Nutrients
Improve fermentation potency with rich, complex nitrogen source for producing enzymes, pharmaceuticals and other bio-based products.

Personal Care Bio-materials
Our diverse portfolio of plant-based ingredients empower your to create solutions for a range of beauty and personal care products.

Pet Products Materials
Provide eco-friendly and cost-effective solutions in pet products such as cat litters with its excellent functional ability.

Industrial-grade Feedstocks
Nature-based feedstocks enable formulators to replace chemical materials with biodegradable alternatives and achieve sustainability goals.

Human Nutrition
Solbar delivers full-range, sustainable nutrition ingredients that create science-backed formulation solutions and meet consumers' premium, evolving nutrition & health pursuit.
Animal Nutrition
Our high-quality, human-grade ingredients for pet food industry can deliver the taste, nutrition and functionality values for various applications, such as pet foods, treats and supplements, meeting the high-standard requirements of pet owners.
Bio-materials Solutions
Consumers are pursuing more sustainable products that are kinder to the earth. We offer a variety of plant-based products as alternatives to chemical raw materials and carbon source, to meet the sustainable and carbon-reduction goals.
Explore More
Secrets of Food
Ingredients







Plant Protein Development and Application Expert
Founded in 2003, Ningbo Solbar Protein Technology Co., Ltd. specializes in plant-protein R&D and manufacturing. With over 30 years of combined international production experience and advanced technologies, we provide diverse soybean-protein solutions to meet global customers’ innovation needs.
Stable Product Supply
A complete industry chain and efficient production ensure reliable sourcing and stable output.
Products & Customer Service
From R&D to delivery, we tailor services to customer needs and help maximize product value.
Sustainability
As the soy protein producer with the most diverse product portfolio in the industry, we are committed to sustainable development across the entire supply chain.



